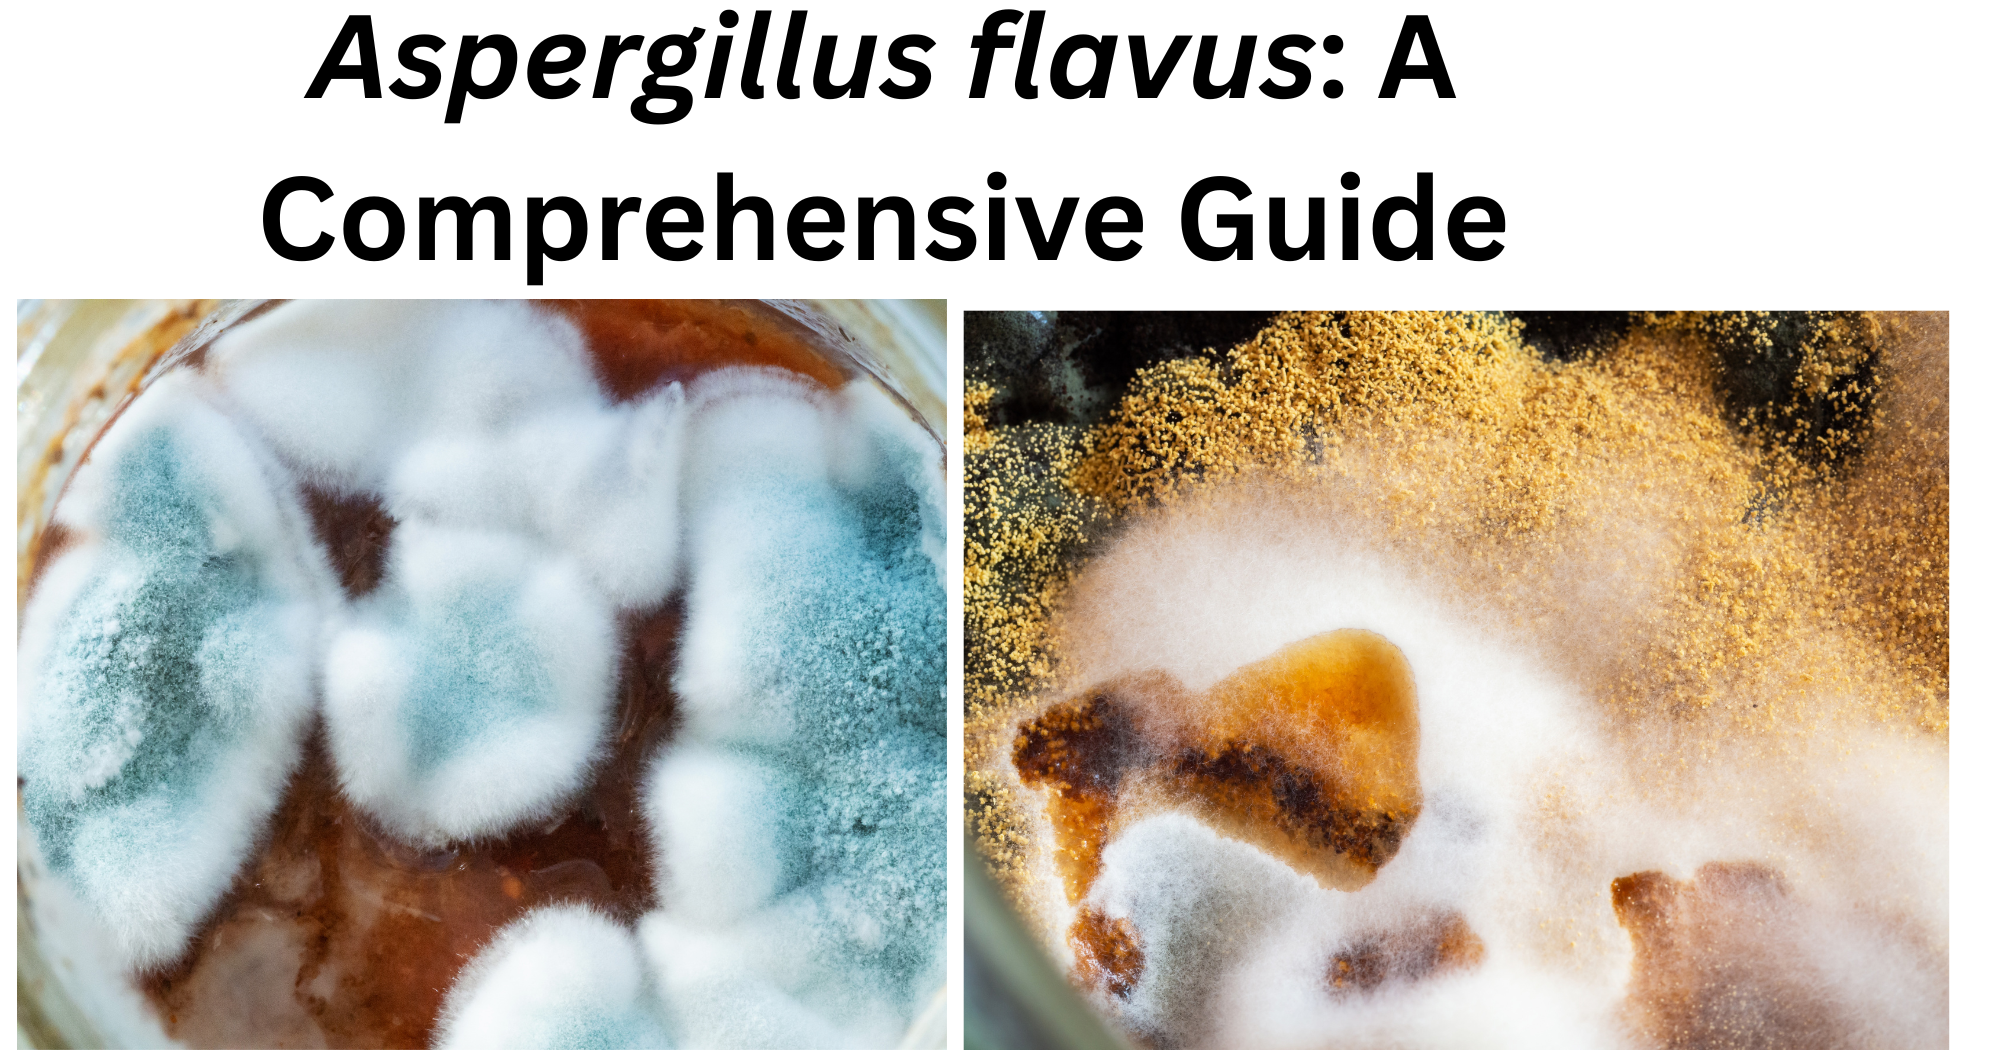
Aspergillus flavus Aspergillus flavus

- Aspergillus flavus is characterized as a prevalent fungus that induces human illnesses and is recognized for producing mycotoxins, particularly aflatoxins.
- It is a saprophytic soil fungus that infects and contaminates seed crops both preharvest and postharvest.
- Over 100 species of Aspergillus have been found, with Aspergillus fumigatus and Aspergillus niger as the primary pathogenic agents, followed by Aspergillus flavus.
- They also induce opportunistic infections, such as aspergillosis, in immunocompromised humans and animals.
Taxonomy and Classification of Aspergillus flavus
Domain: Eukaryota
Kingdom: Fungi
Phylum: Ascomycota
Subphylum: Pezizomycotina
Class: Eurotiomycetes
Order: Eurotiales
Family: Trichocomaceae
Genus: Aspergillus
Species: flavus
Morphology and Microscopy of Aspergillus flavus
Macroscopic or colony morphology: Surface is at first velvety white and then yellow to green or brown, white border might be present. Texture is velvety or cottony. Reverse is usually goldish to red-brown or tan.

b= Reverse of PDA showing colony of A. flavus
https://www.facesoffungi.org/aspergillus-flavus-facesoffungi-number-fof-09597/
Microscopic morphology:
- They have septate hyphae.
- The pattern of conidiophores is long (400-800×8-18µm).
- The walls of conidiophores are rough and spiny on the apex.
- Conidia are 3-6µm in diameter with smooth and rough walls.
- Phialides are both uniseriate and biseriate which are formed over the vesicles which are loosely formed and may cluster to form columns of conidia with age.

Parija, S. C. (2014). Textbook of Microbiology & Immunology (2nd ed). Elsevier Health Sciences APAC.

https://www.shutterstock.com/image-photo/microscopic-view-aspergillus-flavus-globose-vesicle-2647950327
Cultural growth and Characteristics of A. flavus
- Under laboratory conditions, A. flavus exhibits rapid growth and distinctive cultural morphology. When grown on common fungal media such as Potato Dextrose Agar (PDA), Czapek Yeast Extract Agar (CYA), and Malt Extract Agar (MEA), colonies typically mature within 5–7 days at temperatures between 25–30 °C.
- The colony diameter usually reaches 3–7 cm within seven days, depending on environmental conditions and medium composition
- The surface of the colony appears yellow-green due to abundant conidial production. The texture is generally velvety or powdery.
- The reverse side of the colony may appear cream, golden, or tan.
- The fungus demonstrates considerable environmental adaptability. It can grow within a temperature range of approximately 12–48 °C, with optimal growth occurring between 28–35 °C.
- It tolerates a broad pH range (approximately pH 2–11) and can grow at relatively low water activity levels (around 0.78), which explains its frequent occurrence in stored dry commodities.
- In conclusion, Aspergillus flavus is a rapidly growing mold with distinct cultural and microscopic features. Its ability to adapt to diverse environmental conditions and produce aflatoxins makes it a significant organism in food safety, agriculture, and medical microbiology.
Identification Tests of A. flavus
- The principal method for identification is the Lactophenol Cotton Blue (LPCB) mount, which shows septate hyaline hyphae, rough conidiophores, uniseriate or biseriate phialides, and rough globose conidia after the colony observation.
- Toxin production can be tested using Coconut Agar Medium under UV light and verified via TLC, HPLC, or ELISA.
- PCR can also be used to detect various genes which can be produced for the species.
Virulence factors of A. flavus
The various virulent factors that cause pathogenesis in humans are:
Aflatoxin
- Aflatoxins, especially aflatoxin B₁, are secondary metabolites that are hepatotoxic, immunosuppressive, and carcinogenic.
- These toxins contribute indirectly to virulence by harming host tissues, decreasing immune response, and increasing colonization in the host cell.
Hydrolytic enzymes
- Proteases, lipases, and cellulases secreted by A. flavus break down elements of host tissue.
- These enzymes make it possible for the fungus to enter host tissues and use nutrients, which makes it easier for both plants and animals to become infected.
Adhesion
- A. flavus can adhere to surfaces, which protects the septate hyphae from any antifungal agents consumed by hosts.
- This process i.e., adhesion is crucial for the colonization and establishment of infection in the host.
Adaptation of A. flavus in the environment
- The ability of A. flavus to grow at a wide temperature (12-48 °C) and the tolerance of low water activity, enables the survival at wide range of hosts.
- This thermotolerance allows the organism to invade in the tissue of the human hosts such as lungs or alveolar macrophages.
Regulatory genes
- The various genes such as aflR play a major role in virulence. This causes aflatoxin biosynthesis, stress response which coordinates in toxin production.
Pathogenesis of A. flavus
The pathogenesis of Aspergillus flavus begins when airborne conidiospores are inhaled and deposited in the alveoli of the lungs. In healthy individuals, these type of airborne conidiospores are usually phagocytosed and cleared by macrophages and neutrophils present in the alveoli. However, in immunocompromised host for instance, those hosts with neutropenia, the spores can invade the alveoli suppressing the immune system and germinating into septate hyphae in the site of invasion.
The hyphal form is invasive and capable of penetrating lungs tissue by secreting enzymes like proteases, lipases and cellulases. As the infection progresses the hyphae invades nearby the blood vessel and hematogenous dissemination to other organs like kidney, brain and heart.
Additionally, Aspergillus flavus produces their toxins like aflatoxins which suppresses immune response by inhibiting phagocytosis, inducing apoptosis of immune cells.

https://www.sciencedirect.com/science/chapter/edited-volume/pii/B9780443292736000047
Epidemiology of A. flavus
Aspergillus flavus is an opportunistic pathogen that causes invasive pulmonary infections, keratitis, and sinusitis, particularly in immunocompromised people. Fungal proliferation and toxin production are increased by environmental stressors such as drought, high temperatures, and unfavorable storage conditions, which makes them a problem for both agriculture and public health.
The most common species causing invasive sinusitis in immunocompetent patients in the area of Sudan and in the Middle East. It is the most commonly reported food-borne fungus; many of the isolates produce aflatoxins. Aflatoxins constitute a group of highly potent carcinogens and hepatotoxins that are formed in stored grains, corn, and legumes that are subsequently ingested by humans and farm animals. There are various clinical manifestations of Aspergillus flavus infection that have been reported worldwide.
Transmission of A. flavus
- Conidiospores are spread by wind, dust, and mechanical crop handling, which can result in inhalation exposure.
- When consumed, contaminated crops like tree nuts, cottonseed, peanuts, and maize can spread the fungus or its aflatoxins.
- Workers who handle animal feed, stored grains, or decomposing vegetation run a greater risk of exposure through inhalation and contact.
- Immunocompromised people are susceptible to opportunistic infections, which typically start with spore inhalation and result in sinusitis, keratitis, or invasive pulmonary infections.
Clinical Manifestations of A. flavus
In immunocompromised host, Aspergillus flavus may primarily affect the lungs, paranasal sinus, ear, eye, skin and multiple systemic sites. A. flavus can show following manifestations:
- Invasive aspergillosis
It is an infection that spreads quickly in patients with compromised immune systems. The illness is primarily lethal. Aspergillus flavus organisms in immunocompromised hosts cause a disseminated illness that results in abscesses in the viscera, including the liver, spleen, kidney, soft tissues, and bone, as well as endocarditis and endophthalmitis.
- Invasive Sino nasal aspergillosis
It frequently affects diabetic or immunocompromising people. Nasal congestion, swelling, proptosis are symptoms.
- Allergic bronchopulmonary aspergillosis
Wheezing, cough, mucus plugging, respiratory infections are main symptoms. The sensitization is specifically caused due to A. flavus which occurs in asthma or cystic fibrosis patients.
- Keratitis
It often occurs due to ocular trauma, eye surgery or contact lens use. The symptoms include eye pain, redness, blurred vision, photophobia, corneal ulceration, etc.
Laboratory diagnosis of A. flavus
To properly identify Aspergillus flavus, a combination of microscopy, culture, and molecular or biochemical techniques are used in the laboratory.
- Specimen collection
Specimen is collected according to the site of infection. For instance- Sputum, Bronchoalveolar lavage (BAL), skin tissue, corneal scrapings, biopsy specimen, wound scrapings, etc.
- Direct microscopy
Direct KOH (10-20%) preparation of specimen shows non-pigmented, septate hyphae with characteristic dichotomous branching at an angle of 45 degree where biopsy specimens show septate, branching hyphae invading tissues.
- Culture and Colony observation
The specimen cultured on Sabouraud Dextrose Agar (SDA), Potato Dextrose Agar (PDA) or Czapek-Dox Agar are incubated at 25 °C for 3-7 days. A. flavus typically produces velvety white and then yellow to green or brown or white boarder might be present with velvety or cottony texture at front and goldish to red-brown or tan at the reverse.
- Lactophenol cotton blue (LPCB) mount method
LPCB staining is the primary technique for microscopic identification following colony growth. It exhibits the typical characteristics of A. flavus, such as septate hyphae, rough pattern of conidiophores, smooth wall of conidiophores, uniseriate and biseriate phialides.
- Toxin detection tests
Chromatographic techniques like Thin Layer Chromatography (TLC) or HPLC, which help identify toxic strains, can be used to assess the production of aflatoxin in some isolates.
- Molecular tests
For accurate species identification and separation from closely related species, molecular methods like PCR amplification and sequencing of ITS regions or β-tubulin genes are used.
Treatments
The most common use of amphotericin B. Nevertheless, the treatment’s results are unsatisfactory. An alternative medication administered to patients is Capsofungin.
The best way to treat aspergilloma is to surgically remove the fungus ball from the cavity.
Antimicrobial Resistance
Aspergillus flavus is resistant to Amphotericin B, Itraconazole, Voriconazole. However, the frequency of resistance is rare.
Prevention and Control of A. flavus
- To prevent Aspergillus flavus from growing and reduce the possibility of aflatoxin generation, grains, nuts, and cereals should be stored in cold, dry, and well-ventilated settings.
- Aspergillus flavus contamination of crops can be reduced by using excellent agricultural techniques, such as crop rotation, timely harvesting, and adequate field cleanliness.
- To reduce fungal spore inhalation, workers handling stored grains and agricultural commodities should wear protective masks and make sure there is enough ventilation.
- Maintaining efficient air filtration systems and stringent hygiene protocols in hospital settings helps lower exposure to airborne Aspergillus spores, especially in immunocompromised patients.
Conclusion
Aspergillus flavus is a widespread environmental fungus that can be found in soil, decomposing plants, and agricultural items that have been kept, like grains and nuts. It can infect humans by infected wounds or spore inhalation, it primarily affects immunocompromised people and causes diseases like invasive aspergillosis, keratitis, and sinusitis. A. flavus is known to produce aflatoxins, which are dangerous mycotoxins that contaminate food and pose major health hazards, in addition to causing illnesses. To lower morbidity, early discovery and appropriate treatment are crucial, particularly in areas with warm climates where the fungus is common. Controlling the spread and effects of Aspergillus flavus requires preventive measures such appropriate food storage, routine crop monitoring for aflatoxin contamination, and upholding hygienic ambient conditions.
References
1. Aspergillus flavus. (2026). In Wikipedia. https://en.wikipedia.org/w/index.php?title=Aspergillus_flavus&oldid=1340057830
2. Barton, R. C. (2013). Laboratory Diagnosis of Invasive Aspergillosis: From Diagnosis to Prediction of Outcome. Scientifica, 2013, 459405. https://doi.org/10.1155/2013/459405
3. Bertin-Biasutto, L., Paccoud, O., Garcia-Hermoso, D., Denis, B., Boukris-Sitbon, K., Lortholary, O., Bretagne, S., Gits-Muselli, M., Herbrecht, R., Letscher-Bru, V., Danion, F., Cassaing, S., Morio, F., Nourrisson, C., Pihet, M., Sasso, M., Desoubeaux, G., Durieux, M.-F., Bonhomme, J., … Lanternier, F. (n.d.). Features of Invasive Aspergillosis Caused by Aspergillus flavus, France, 2012–2018—Volume 31, Number 5—May 2025—Emerging Infectious Diseases journal—CDC. https://doi.org/10.3201/eid3105.241392
4. Cotty, P. J. (1989). Virulence and cultural characteristics of two Aspergillus flavus strains pathogenic on cotton. Phytopathology, 79(7), 808–814.
5. Leema, G., Kaliamurthy, J., Geraldine, P., & Thomas, P. A. (2010). Keratitis due to Aspergillus flavus: Clinical profile, molecular identification of fungal strains and detection of aflatoxin production. Molecular Vision, 16, 843–854.
6. Morphology of Aspergillus flavus. (n.d.). Retrieved March 2, 2026, from https://encyclopedia.pub/entry/10330
7. Parija, S. C. (2014). Textbook of Microbiology & Immunology (2nd ed). Elsevier Health Sciences APAC.
8. (PDF) Ecology, development and gene regulation in Aspergillus flavus. (n.d.). ResearchGate. Retrieved March 2, 2026, from https://www.researchgate.net/publication/43289878_Ecology_development_and_gene_regulation_in_Aspergillus_flavus
9. Suarez, O. J., Ruiz-Ayala, D. C., Contreras, L. R., Forero, M. G., Medrano-Hermosillo, J. A., & Rodriguez-Mata, A. E. (2025). Morphological Characterization of Aspergillus flavus in Culture Media Using Digital Image Processing and Radiomic Analysis Under UV Radiation. Agriculture, 15(17). https://doi.org/10.3390/agriculture15171888
10. Walsh, T. J., Hayden, R. T., & Larone, D. H. (2018). Larone’s Medically Important Fungi: A Guide to Identification. ASM Press. https://doi.org/10.1128/9781555819880
